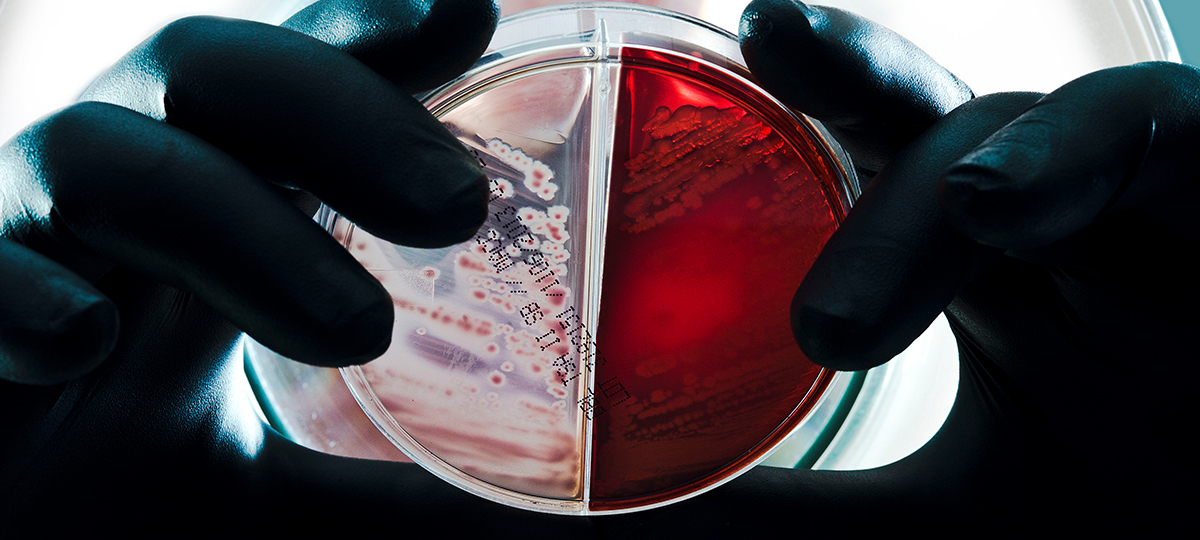

Microbial Solutions
|
Eureka Staff
The PharmaLab Congress
Quandaries in Endotoxin Testing, Id’ing bacteria and analyzing antibodies. CRL scientists present at annual meeting in Germany
The Limulus Amebocyte Lysate (LAL) test, named for a compound in horseshoe crabs that reacts with exquisite sensitivity to the presence of gram-negative bacteria, is a common quality control tool for pharmaceutical manufacturers. Companies use the LAL kits as an end-product test for endotoxins in human biological products and medical devices. In fact, millions of these tests are performed yearly around the world.
 But what happens when the human error compromises the integrity of the data produced during manufacturing and quality control testing of pharmaceutical products? At next week’s 2017 PharmaLab Congress in Germany Nov. 7-8, Matthew Paquette, a Product Specialist II with Charles River Microbial Solutions and an expert in endotoxin testing, will be talking about how industry can apply the principals of human error risk reduction to data integrity.
But what happens when the human error compromises the integrity of the data produced during manufacturing and quality control testing of pharmaceutical products? At next week’s 2017 PharmaLab Congress in Germany Nov. 7-8, Matthew Paquette, a Product Specialist II with Charles River Microbial Solutions and an expert in endotoxin testing, will be talking about how industry can apply the principals of human error risk reduction to data integrity.
“As more and more laboratory testing shifts from observation based qualitative methods to less subjective quantitative methods, focus on data integrity becomes more critical to ensure overall product quality and patient safety,” says Paquette. “Although quantitative methods allow for more precise data analysis, gaps in the way we address human error present challenges for the integrity of the data we produce during manufacturing and quality control testing of pharmaceutical products.”
Paquette says utilizing an organized, risk based approach to closing the human error gaps in our processes allows us to demonstrate to all stakeholders that the data we use to prove product quality is integral and accurate.
So why are these data problems such a hot topic right now? In recent years, data integrity lapses have been brought to the forefront by regulatory agencies citing violations and inadequacies in findings from inspections, audits, and warning letters. “When we adapt and learn from these mistakes it’s important to evaluate our processes to minimize the risk for human error as it pertains to the integrity of the data we collect as an industry. Reducing the risk for human error in our manufacturing and laboratory processes will ensure that we comply with data integrity laws and regulations while building quality into our everyday practices and keeping our patients and our drugs safe,” says Paquette.
Bacterial Detectives
Since the mid-1990s, the standard tool used by scientists to identify bacteria has been to sequence the small subunit (16S) ribosomal RNA gene (the 16S rDNA). Sequencing the 16S rDNA allows for comparative analysis of published sequences in microbial databases; you can determine if you have uncovered something that has been seen before or something that looks to be entirely new.
Why is accurate identification of bacteria—and other microbes—such a hot topic. Charles River Senior Scientist SunHee Hong, PhD, an experienced phylogeneticist who was part of a team that recently discovered a novel bacterial strain in Korea, will be also be presenting a talk at the 2017 PharmaLab Congress on why knowing precisely what microbes are lurking in your facility matter to a company’s future. “Bacterial Identification in the biopharmaceutical industry, especially in manufacturing facilities, is very important because an occurrence of problematic microorganisms in a company’s final product could be harmful for the end user and detrimental to their finances and reputation,” says Hong. “For this reason, the Environmental Monitoring (EM) Program was established and has become a regulatory requirement for most manufacturers. However, the EM program is only effective if an accurate identification is provided for the organisms recovered from the facility, so the information gathered can be used to understand the microbial control through tracking and trending and dictate appropriate remediation activities.“
Part of Hong’s talk next week will focus on the challenges in using genotypic identification methods in today’s world and alternatives to the 16S rRNA gene, which is relatively easy to generate and analyze data but nonetheless has limitations due to the high percentage of 16S rRNA gene sequence similarity between closely related species. “To overcome this problem, the use of alternative molecular markers has been proposed,” says Hong. “An essential housekeeping gene such as recA, rpoB and gyrB have been applied in bacterial classification and have proven useful for the identification of closely related bacterial species.”
Bioassays for Therapeutic Antibodies
Lastly, Ulrike Herbrand, PhD, Scientific Supervisor for Research & Development at Charles River’s Biopharmaceutical Site in Erkrath, Germany, will be delivering a talk at the PharmaLab Congress on Bioassays for Therapeutic Proteins.
An increasing percentage of the drugs moving to market in recent years have been monoclonal antibodies (mAbs) and as the patents on these drugs expire come new opportunities for developers to introduce biosimilars of these biologics. “Complex protein therapeutics like mAbs require comprehensive testing of the biological activity during the whole life cycle to ensure quality, safety and efficacy,” says Herbrand. “For this purpose, functional bioassays reflecting the drug’s mechanism of action (MOA) are required by the regulatory authorities.”
Herbrand’s talk will be focusing on the challenges developers face in determining which MoAs their antibody candidates follow. “The assays used need to be reliable, reproducible and precise, which is reflected by the rising acceptance of surrogate approaches whenever primary MoA assays are found to be tedious, time consuming and sometimes highly variable,” says Herbrand.
